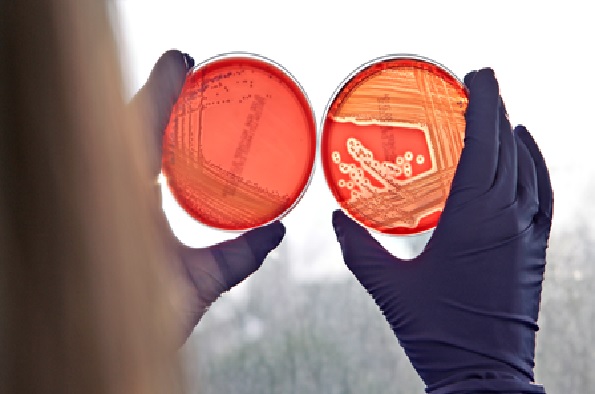

The Staphylococcus Aureus Type VII Protein Secretion System
- Jay Hinton
- Suitable for: Staff and students with an interest in Genomes, Systems and Therapeutic Targeting
- Admission: Free
Add this event to my calendar
Click on "Create a calendar file" and your browser will download a .ics file for this event.
Microsoft Outlook: Download the file, double-click it to open it in Outlook, then click on "Save & Close" to save it to your calendar. If that doesn't work go into Outlook, click on the File tab, then on Open & Export, then Open Calendar. Select your .ics file then click on "Save & Close".
Google Calendar: download the file, then go into your calendar. On the left where it says "Other calendars" click on the arrow icon and then click on Import calendar. Click on Browse and select the .ics file, then click on Import.
Apple Calendar: The file may open automatically with an option to save it to your calendar. If not, download the file, then you can either drag it to Calendar or import the file by going to File >Import > Import and choosing the .ics file.
The type VII protein secretion system (T7SS) plays a critical role in the virulence of human pathogens including Mycobacterium tuberculosis and Staphylococcus aureus. Published studies have shown that this secretion pathway plays a very significant role in the ability of S. aureus to establish persistent infections. Our overall aim is to elucidate the mechanism of protein secretion by the S. aureus T7SS machinery and to identify secreted substrate proteins. Recently we have shown that some strains of S. aureus secrete a large nuclease toxin, EsaD, by this pathway. The toxic activity of EsaD is neutralised during its biosynthesis through complex formation with an antitoxin, EsaG, which binds to its C-terminal nuclease domain. Secretion of EsaD is dependent upon a further accessory protein, EsaE, that probably targets the EsaDG complex to the secretion apparatus. We have shown that EsaD exhibit significant antibacterial killing activity against a sensitive strain and most likely plays a role in colonisation. Very recently we have identified a further secreted substrate of the T7SS that appears to be partially responsible for the virulence phenotype of the T7SS in an animal model of infection. Thus this secretion system has anti-bacterial and anti-eukaryotic targets.